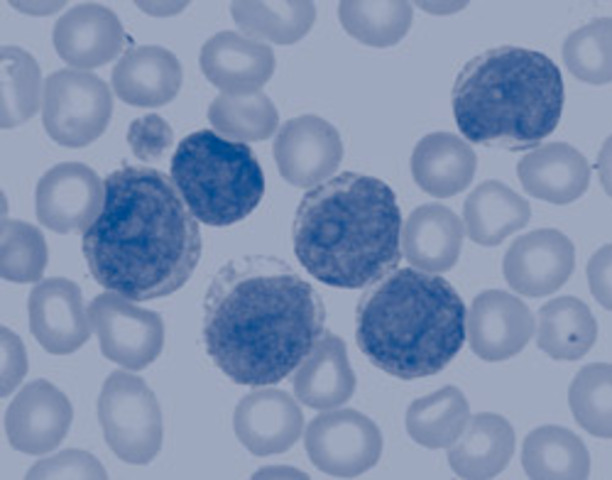
A RARE CASE!

-
-
A rare case of female-to-female sexual transmission of HIV was reported. Doctors suggested the woman may have been infected through sharing sex toys after drug resistance tests found striking similarities between the HIV strains in her and her female partner.
-
An expert group reaffirmed that unsafe sexual practices were responsible for the majority of HIV infections in sub-Saharan Africa. This announcement was a response to claims made in 2002 that unsafe medical practices were to blame for an important portion of HIV transmission in Africa.
-
The first of a new type of anti-HIV drug gained approval in the United States of America.
-
The US senate approved President Bush's international AIDS bill in May, setting a timetable for spending $15 billion over five years.
-
The World Health Organization, WHO, declared that the failure to deliver treatment to nearly six million people with HIV/AIDS in developing countries was a global public health emergency.
-
The U.S. Congress authorizes the first $350 million for United States President's Emergency Program for AIDS Relief, PEPFAR.
-
The U.S. Food and Drug Administration (FDA) approves the use of oral fluid samples with a rapid HIV diagnostic test kit that provides the result in approximately 20 minutes.
-
Women Ages 15-24 got included in the high risk category.
-
47% of women are living with HIV
-
There were 3.1 million deaths due to HIV/Aids.
2.6 million were adults & 510,000 children under age 15 died due to HIV/Aids. :( -
The rate (per 100,000) persons of HIV/Aids diagnosis of American Indians and Alaska Natives was 10.6, compared with 72.8 for African Americans, 9.0 for Whites, and 7.6 for Asians and Pacific Islanders.
-
Nelson Mandela announced that his eldest son Makgatho had died of Aids, aged 54.
-
The rate of Aids diagnosis for black women (45.5/100,000 women) was approximately 23 times the rate for white women (2.0/100,000 women) and 4 times the rate for hispanic women (11.2/100.000).
-
Black and Hispanic women account for 81% of the women living with HIV/Aids in 2005 who acquired HIV through high-risk heterosexual contact.
-
Of the estimated 68 children whom Aids was diagnosed during 2005, an estimated 67 had been infected with HIV perinatally.
-
More infections occured among young people under 30 (aged 13-29) than any other age group (34% or 19,200), followed by individuals 30-39 (31% or 17,400). This confirms that HIV is an epidemic primarily of young people and underscores the critical need to reach each new generation of young people with HIV prevention series.
-
This day is the first annual National Women and Girls HIV/Aids Awareness Day in the United States. It is a day to "Share the knowledge and take Action". A day where the officials share the facts about HIV/Aids as well as take actions by telling women and girls how to prevent HIV/Aids, getting more of them to get tested, providing services to those living with HIV/Aids.
-
This day marks 25 years since the first AIDS cases were reported.
-
Gil Scott-Heron was an American soul and jazz poet and known for his work as a spoken word performer in the 1970s and 80s. He was infected with HIV/Aids in 2006 while he was in prison. This guy died in May 27, 2011, aged 62.
-
The U.S. Centers for Disease Control and Prevention (CDC) release revised HIV testing recommendations for healthcare settings, recommending routine HIV screening for all adults, aged 13-64, and yearly screening for those at high risk.
-
The U.S. Congress reauthorizes the Ryan White Act for the third time. The compromise addressed concerns surrounding the equitable distribution of federal AIDS funds across the country.
A list shows items. A timeline shows sequence.
Use Timetoast to make dates, milestones, and turning points easier to understand in a clear visual format. Timetoast is a timeline maker for work, school, research, and stories.